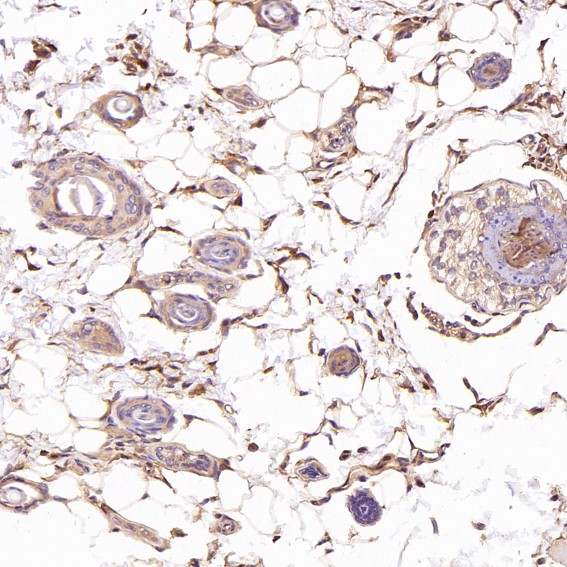
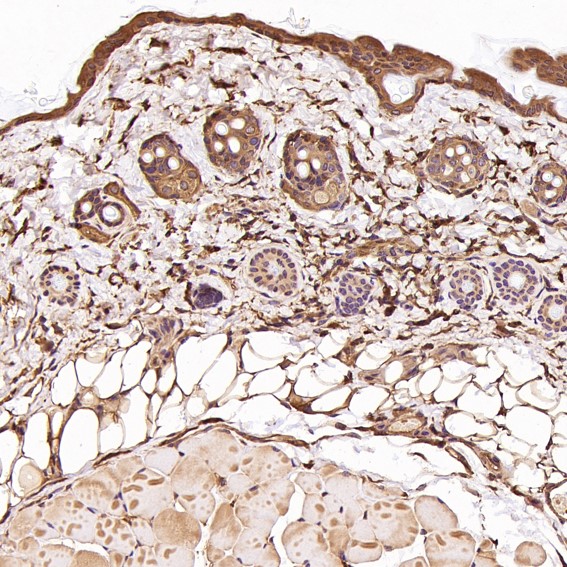

Rabbit Monoclonal to CDC42
货号:
P17438
别名:
CDC42; CDC42Hs; G25K; TKS;;CDC42
应用:
WB;IHC;IP;FCM
反应种属:
Human,Mouse,Rat
抗体类型:
Primary antibody
Swissprot:
P60953
规格:
目录价
在线咨询
Description |
|---|
Plasma membrane-associated small GTPase which cycles between an active GTP-bound and an inactive GDP-bound state. In active state binds to a variety of effector proteins to regulate cellular responses. Involved in epithelial cell polarization processes. Regulates the bipolar attachment of spindle microtubules to kinetochores before chromosome congression in metaphase. |
Specification |
|
|---|---|
| Aliases | CDC42; CDC42Hs; G25K; TKS;;CDC42 |
| Swissprot | P60953 |
| WB Predicted band size | 21 kDa |
| Host/Isotype | Rabbit IgG |
| Antibody Type | Primary antibody |
| Storage | Store at 4°C short term. Aliquot and store at -20°C long term. Avoid freeze/thaw cycles. |
| Species Reactivity | Human,Mouse,Rat |
| Immunogen | A synthesized peptide derived from human CDC42 |
| Formulation | Purified antibody in PBS with 0.05% sodium azide,0.05% BSA and 50% glycerol. |
Application |
|
|---|---|
| WB | 1/1000-1/2000 |
| IP | 1/20-1/50 |
| IHC | 1/100-1/200 |
| FCM | 1/20-1/100 |
Product Image
-
All lanes use the Antibody at 1:2K dilution for 1 hour at room temperature.

-
All lanes use the Antibody at 1:2K dilution for 1 hour at room temperature.

-
All lanes use the Antibody at 1:2K dilution for 1 hour at room temperature.

-
All lanes use the Antibody at 1:1K dilution for 1 hour at room temperature.

-
Immunohistochemical analysis of paraffin-embedded Rat skin, using the Antibody at 1:200 dilution.

-
Immunohistochemical analysis of paraffin-embedded Human esophageal carcinoma, using the Antibody at 1:100 dilution.

-
Immunohistochemical analysis of paraffin-embedded Human colon, using the Antibody at 1:100 dilution.

-
Immunohistochemical analysis of paraffin-embedded Human Hodgkin's lymphoma, using the Antibody at 1:200 dilution.

-
Immunohistochemical analysis of paraffin-embedded Mouse skeletal muscle - gastrocnemius , using the Antibody at 1:200 dilution.

-
Immunohistochemical analysis of paraffin-embedded Mouse skin, using the Antibody at 1:200 dilution.

鄂公网安备42018502007531号
鄂公网安备42018502007531号

